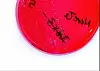

Norsk svinekjøtt fritt for Salmonella
Det norske overvåkings- og kontrollprogrammet for Salmonella dokumenterer at forekomsten av Salmonella hos levende husdyr og i produkter av disse har vært svært lav gjennom mange år.
Det norske overvåkings- og kontrollprogrammet for Salmonella dokumenterer at forekomsten av Salmonella hos levende husdyr og i produkter av disse har vært svært lav gjennom mange år.